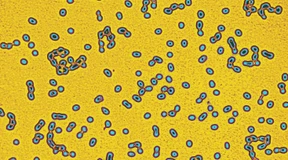
Wie Bakterien Antibiotikaresistenzen weitergeben

So wird das nichts mit der Arzneimittel-Souveränität
Die Bundesrepublik wollte bei lebensrettenden Medikamenten weniger abhängig von China werden. Ein Gesetz sollte die Sache regeln. Gebracht hat es nicht viel.

Während Trump bei den Arzneipreisen Druck macht, tritt der Pharmadialog zwischen Industrie, Krankenkassen und Regierung auf der Stelle. Verbandschefin Dorothee Brakmann hat eine Idee, die eine große Entlastung bringen könnte.

Die Bundesrepublik wollte bei lebensrettenden Medikamenten weniger abhängig von China werden. Ein Gesetz sollte die Sache regeln. Gebracht hat es nicht viel.

Wollen wir gesund bleiben, müssen wir gute Bakterien in unserem Darm mit geeigneter Nahrung füttern und düngen. Hier erfahren Sie, worauf dabei unbedingt zu achten ist – und was Probiotika aus der Apotheke bringen.

Krankheitskeime werden gegen immer mehr Antibiotika resistent. Mit international abgestimmten Strategien kämpfen Mediziner dagegen an. Denn neue Medikamente allein sind nicht die Lösung.

Seit einem Vierteljahrhundert wird das Mikrobiom des Darms intensiv erforscht. Eine Darmspezialistin erklärt, wie die Bakterien unser Immunsystem, unsere Fitness und unsere Psyche beeinflussen.

In der Medizin liegen Wahrheit und Irrtum oft nah beeinander. Sander L. Gilman zeigt unter anderem am Beispiel der Akupunktur, wie sich die Grenzen zwischen seriöser Wissenschaft und Scharlatanerie ständig verschieben.

Mehr als eine Millionen Menschen sind 2021 gestorben, weil sie sich mit resistenten Bakterien infiziert hatten. Das zeigt ein neuer Bericht der WHO. Besonders betroffen: Südostasien und der östliche Mittelmeerraum.

Ärzte bieten oftmals Tests oder Therapien an, die im besten Fall nichts nutzen, im schlimmsten Fall viel kosten und Risiken bergen. 24 davon haben Forscher nun als nutzlos identifiziert. Ein Interview mit der Studienleiterin.

Auch in diesem Jahr stockt der Nachschub vieler Medikamente. Europas größter Medikamentenhändler, Phoenix Pharma, glaubt nicht an eine schnelle Beseitigung der Engpässe.

Viele Bakterien lassen sich nicht mehr mit Antibiotika bekämpfen. Sind Bakteriophagen die Rettung? Eine Frankfurter Uni-Medizinerin untersucht, was diese viralen Keimkiller können.

Immer mehr Bakterien sind multiresistent. Es gibt mittlerweile sogar Keime, gegen die praktisch kein bekanntes Antibiotikum mehr wirkt. Noch haben Ärzte einige Mittel in Reserve, doch neue Medikamente werden dringend gebraucht.

In Frankfurt fahren am Freitag keine U-Bahnen und Straßenbahnen. Hessische Ärzte haben 2023 rege Antibiotika verschrieben. Und auf eine Vielzahl von Volkshochschulkursen könnte Mehrwertsteuer anfallen. Die F.A.Z.-Hauptwache blickt auf die Themen des Tages.

Der Verbrauch von Antibiotika in Deutschland nimmt zu und liegt wieder über dem Vor-Corona-Niveau. Besonders der Einsatz von Reserveantibiotika steht dabei unter Beobachtung.

Sie helfen, Krankheiten zu heilen, Symptome zu lindern und die Lebensqualität zu verbessern: Keiner von uns möchte auf bestimmte Medikamente verzichten. Doch was gilt es bei ihrer Einnahme zu beachten?

Können hochverdünnte Homöopathika den Einsatz von Antibiotika reduzieren? Die bayerische Landesregierung wollte die Frage aufwändig untersuchen lassen. Doch kann nun nicht wie geplant fertiggestellt werden.

Der Chef des Pharmakonzerns Sandoz, Richard Saynor, über den größten Patentablauf in der Geschichte der Branche, Nachahmerprodukte für Abnehmmittel und knapp werdende Medikamente.

Dass Antibiotikaresistenzen ernste Folgen haben, ist klar – eine Studie beschreibt nun, wie sie aussehen könnten. Bis 2050 könnten es zu gut 39 Millionen Todesfällen kommen.

Der Erfolg vieler Krebstherapien hängt von der Vielfalt der Mikroflora ab. Müssen auch Antibiotika eingenommen werden, sollten Patienten und Ärzte unbedingt auf die richtige Diät achten.

Gegen viele krank machende Bakterien gibt es kaum noch Hilfe. Es gibt aber Strategien, die Antibiotikakrise in den Griff zu bekommen.

Serbiens Hauptstadt hat fast zwei Millionen Einwohner – aber keine Kläranlage. Das ganze Abwasser gelangt so ungefiltert in den Fluss.

Wirtschaftsminister Robert Habeck bricht am Montag zu einer „Pharma-Reise“ auf. Die Branche sieht strukturelle Probleme am Standort Deutschland.

Immer mehr Bakterien sind gegen die gängigen Antibiotika resistent. Auf dem Internisten-Kongress in Wiesbaden wurden jetzt Wege für einen besseren Einsatz der Wirkstoffe vorgestellt.

In der Grippesaison gibt es für Sportler einiges zu beachten. Zwei Mediziner geben Tipps zum Sport trotz Erkältung und räumen mit einem verbreiteten Mythos auf.
Resistenzen gegen eine wichtige Klasse von Antibiotika werden über ein ringförmiges DNA-Stück weitergegeben. Forscher aus Gießen haben es in vielen Bakterien nachgewiesen.

Die Zahl der an der Geschlechtskrankheit Gonorrhö Erkrankten hat zugenommen. Erste Daten zu einem neuen Antibiotikum sind vielversprechend: Es ist auch gegen multiresistente Keime wirksam.

In nördlichen Regionen Chinas hatte es zuletzt eine ungewöhnliche Häufung von nicht diagnostizierten Lungenentzündungen bei Kindern gegeben. Die WHO bat China daraufhin um Aufklärung. Nun gibt sie Entwarnung.

Mit Subventionen Österreichs verzichtet Sandoz auf die Einstellung der Penicillinproduktion in Tirol.

Ein Labor in Dresden untersucht den Drogenkonsum der Deutschen – anhand der Rückstände im Abwasser. Die Analysen zeigen: Bestimmte Stoffe werden dort viel konsumiert, wo man leicht an sie rankommt.

Schmerzmittel, Antibiotika, Fiebersäfte: Die Produktion von Arzneimitteln soll bis zum technischen Limit erhöht werden, kündigt Gesundheitsminister Lauterbach an. Apotheken sollen mehr Verantwortung übernehmen.

Dem Krankenhauskeim Acinetobacter baumannii fallen jährlich Tausende von Menschen zum Opfer. Frankfurter Forscher haben herausgefunden, wie sich das Bakterium an seine Umwelt anpasst.

Lange Zeit waren Nanopartikel nur etwas für die Grundlagenforschung. Aber mittlerweile sind die winzigen Objekte in schonendem Motoröl, in Socken und Arzneimitteln angekommen - Grund zur Sorge?

Der massiv gestiegene Gebrauch von Desinfektionsmitteln könnte Resistenzen bei Bakterien fördern. Forscher warnen vor einer Verschärfung der Antibiotikakrise.

Die Antibiotika-Forschung war einst schwer umworben. Heute haben Pharmakonzerne wenig Anreize, neue Präparate zu entwickeln. Was die EU dagegen tun will.

Antibiotika fehlen, Arzttermine sind kaum zu bekommen – im Gesundheitssystem gibt es viel zu tun. Dafür braucht Deutschland ein politisches Talent.

Wichtige Medikamente sind in diesen Tagen in Deutschland abermals knapp – vor allem für Kinder. Nicht nur die Eltern besorgt das. Und wie geht es jetzt weiter?

Im Frankfurter Bahnhofsviertel wird weniger Crack konsumiert. Ein junger Mann brach ein Studium für eine Lehre ab und ist nun Landesbester. Und bei Antibiotika hofft Hessen auf das Ausland. Die F.A.Z.-Hauptwache.

Auch Baden-Württemberg und Brandenburg haben inzwischen Notmaßnahmen gegen den Medikamentenmangel für Kinder ergriffen. Arzneimittelhersteller und Krankenkassen fordern aber langfristige Lösungen.